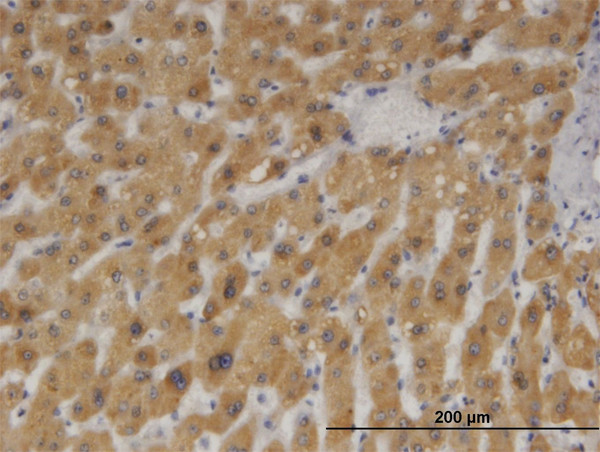
CYB5A Antibody in Immunohistochemistry (Paraffin) (IHC (P))

Search
Abnova
CYB5A Monoclonal Antibody (4C2)
{{$productOrderCtrl.translations['antibody.pdp.commerceCard.promotion.promotions']}}
{{$productOrderCtrl.translations['antibody.pdp.commerceCard.promotion.viewpromo']}}
{{$productOrderCtrl.translations['antibody.pdp.commerceCard.promotion.promocode']}}: {{promo.promoCode}} {{promo.promoTitle}} {{promo.promoDescription}}. {{$productOrderCtrl.translations['antibody.pdp.commerceCard.promotion.learnmore']}}
产品信息
H00001528-M05
种属反应
宿主/亚型
分类
类型
克隆号
抗原
偶联物
形式
浓度
规格
纯化类型
保存液
内含物
保存条件
运输条件
产品详细信息
Sequence of this protein is as follows: MAEQSDEAVK YYTLEEIQKH NHSKSTWLIL HHKVYDLTKF LEEHPGGEEV LREQAGGDAT ENFEDVGHST DAREMSKTFI IGELHPDDRP KLNKPPETLI TTIDSSSSWW TNWVIPAISA VAVALMYRLY MAED
靶标信息
Cytochrome b5 is a membrane-bound member of the cytochrome b family. A heme protein that functions as an electron carrier for many membrane-bound oxygenases, cytochrome b5 possesses two heme groups, which are not covalently attached to the protein. Two isoforms of cytochrome b5, a microsomal membrane-bound form and a cytoplasmic form, are produced by alternative splicing. Mutations in cytochrome b5 are associated with Leber's hereditary optic neuropathy and with myopathy.
仅用于科研。不用于诊断过程。未经明确授权不得转售。
篇参考文献 (0)
生物信息学
蛋白别名: CYB5; Cytochrome b5; cytochrome b5 type A (microsomal); epididymis secretory sperm binding protein; MCB5; Microsomal cytochrome b5 type A; type 1 cyt-b5
基因别名: CYB5; CYB5A; MCB5; METAG
UniProt ID: (Human) P00167
Entrez Gene ID: (Human) 1528